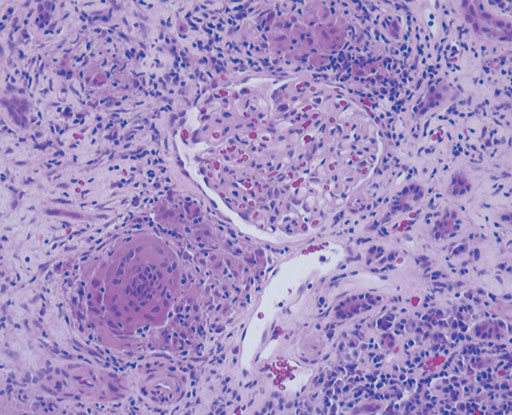

レントゲンカンファレンス症例・解答と解説
第21回 日本画像医学会 (2002年2月)
No.12症例4:71歳、男性
診断:Sarcoidosis
- 【解説】
- Sarcoidosisは通常,縦隔および両側肺門部の腫大をともなって発症するが,まれに皮膚,中枢神経,軟部腫瘍で発症することがある.腎病変は,高カルシウム血症にともなう腎結石や腎障害がみられるのが一般的であるが,まれに多発性のnoduleを形成することが知られている.腎臓の多発性結節の鑑別としては,von Hippel-Lindau病に認められる腎癌,転移性腎腫瘍,悪性リンパ腫,結核等の感染症,腎盂腎炎が鑑別に上がる.今回の症例では筋肉内に比較的,均一に造影される結節が認められることからsarcoidosisの診断が示唆される.転移性腫瘍は通常,内部に壊死を伴って不均一に造影される.悪性リンパ腫ではdiffuseな筋肉の腫大を呈することが多い.Sarcoidosisの筋病変は単発性または多発性の結節を呈するnodular typeとmyopathic typeが知られている.結節型はMRIでは,T1強調像,T2強調像,造影T1強調像のいずれのsequenceにおいても中心部に不規則な星ぼう状の低信号(dark star sign)を呈するのが特徴的である.Myopathic typeではMRIでは異常信号として捉えにくいが,67Gaシンチでは筋肉に沿って瀰漫性の集積が認められる.実際の症例では皮膚,腎臓,筋肉いずれの病変からもbiopsyによりsarcoidosisの診断が得られている.腎臓の病理では系球体周囲に非乾酪性肉芽腫の形成を認め,また一部に巨細胞も認める.
図3 HE染色(×200)
図3 HE染色(×200) 図4 HE染色(×200)
図4 HE染色(×200)
- 【参考文献】
-
- Rohatgi PK, Liao TE, Borts FT. Pseudotumor of left kidney due to sarcoidosis. Urology. 1990; 35: 271-5.
- Hughes JJ, Wilder WM. Computed tomography of renal sarcoidosis. J Comput Assist Tomogr. 1988; 12: 1057-8.
- Otake S, Ishigaki T. Muscular sarcoidosis. Semin Musculoskelet Radiol. 2001; 5: 167-70.
- Otake S. Sarcoidosis involving skeletal muscle: imaging findings and relative value of imaging procedures. AJR Am J Roentgenol. 1994; 162: 369-75.